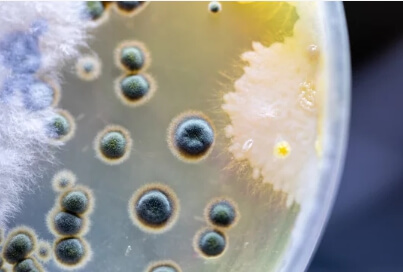
탄저균 집단 감염

티스토리 뷰
인도네시아에서 탄저균 감염으로 사망자와 양성 반응을 보인 사람들이 나왔습니다.
고기를 나눠 먹은 주민들 사이에서 탄저균 감염이 이뤄져 현지가 발칵 뒤집혔다고 합니다.

현재 인도네시아에서는 3명이 사망하고 수십 명이 탄저균으로 치료를 받고 있습니다.
5일 안타라 통신에 따르면 인도네시아 욕야카르타주 쿠눙키둘 카운티 정부는 주민 3명이 탄저균에 감염돼 숨졌다고 밝혔습니다.
또한 사망자들과 같은 쇠고기를 나눈 지역 주민들을 대상으로 혈액 검사를 실시한 결과 93명이 탄저균 양성 반응을 보였으며, 그중 일부는 병원에서 치료를 받고 있다고 말했습니다.
현지 보건당국은 이슬람 희생제의 날 축제인 이드 알 아다를 기념해 나눠 먹은 쇠고기 사이에 탄저균이 퍼진 것으로 추정하고 있습니다.
특히 이들이 먹은 쇠고기에는 질병으로 폐사한 소를 도살한 고기가 포함된 것으로 전해졌습니다.



탄저병은 소나 양 같은 초식동물과 인간을 감염시키는 질병입니다. 보통 탄저균이 들어 있는 풀을 먹는 가축이 감염되는데, 이를 먹으면 사람에게도 전염될 수 있습니다.
탄저균에 감염돼 탄저균에 걸리면 설사, 피부궤양, 붓기 등의 증상이 나타납니다.
질병 자체는 항생제와 잘 어울리는데 탄저균에 의해 생성되는 독소는 미량에 불과합니다 또한 치명적이기 때문에 생물학적 무기로도 사용됩니다.
인도네시아 당국은 현지 농장을 '레드 존'으로 지정하고, 현지에서 공급되는 쇠고기를 구별할 수 있는 기간을 120일로 하였습니다.
게다가, 지역 농부들은 그들의 몸이 노출되는 것을 막기 위해 부츠와 장갑을 덮은 채로 일하도록 권고받았습니다.
